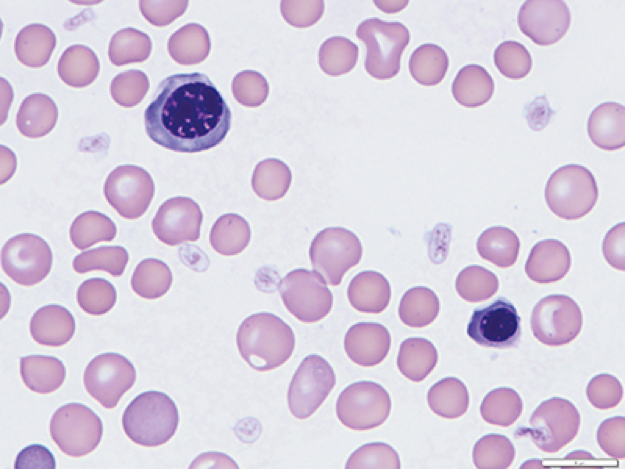

Perro pastor alemán con infecciones de piel recurrentes e intolerancia al ejercicio.
Matias, pastor alemán de 9 años, sin castrar se presenta con historia de problemas de piel recurrentes, e intolerancia al ejercicio. En el examen físico, muestra alopesia ventral, y áreas de liquenificación cutánea. Para tomar las biopsias de piel se practica un panel preanestesico básico y a continuación se muestran los resultados del equipo de hematología y una imagen proveniente del microscopio.
Considere la siguiente pregunta: Identifique las células vistas en el microscopio.
¿Considera usted que el recuento de leucocitos es correcto?
| Analito | Resultado | Rango de referencia | Conclusión |
| Recuento total GB | 28.000 | 4.,000-14000 | Aumentados |
| Neutrófilos | 15.880 | 2.100-11.200 | Aumentados |
| Linfocitos | 9.070 | 780-3.360 | Aumentados |
| Monocitos | 890 | 0-1.200 | En el rango |
| Eosinófilos | 1.320 | 0-1.200 | Aumentado |
| Basófilos | 940 | 0-130 | Aumentados |
| Hematocrito | 31% | 37-50 | Disminuido |
| Recuento reticuloc. | 80 | 6-81 | En el rango |
| Plaquetas | 564.000 | 200.000-500.000 | Leve incremento |